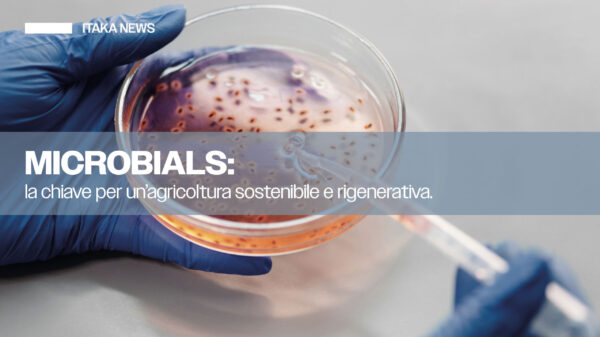

Una partnership per l’agricoltura sostenibile
Itaka e Accademia Suolo Connesso Itaka si avvale della collaborazione dell’Accademia Suolo Connesso per promuovere modelli di agricoltura sostenibile basati su solide basi scientifiche.Grazie alla consulenza diretta in campo, Itaka integra le competenze dell’Accademia per offrire agli agricoltori interessati un report dettagliato e scientifico, in grado di valutare il reale livello di sostenibilità della propria…